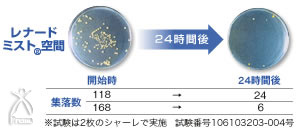
ミスパ ビューティー・ミニ：クロカビの検証試験

6.4ミクロンの微粒温熱ミスト『Mispa ミスパ ビューティー・ミニ』
6.4ミクロンの微粒温熱ミストとマイナスイオンが発生して、自宅の浴室が心地よい本格的ミストサウナに変わります。
「Mispa ミスパ ビューティー・ミニ」は販売終了いたしました。
ご愛顧ありがとうございました。
どんなお風呂にも後付簡単設置!
電気もガスも使わず給湯のみで運転
お風呂の中がレナードミストいっぱいにあふれます。

|
| ▼買い物かご |
|
顔だけじゃなく、髪も、ボディも、全て磨いてなりたい自分になっちゃおう! |
|
|
||
| 微粒レナードミストのすすめ | ||
|
|
||


|
| ▼買い物かご |
|
|
||
| 「ミスパ ビューティー・ミニ」取り付けチェック | ||
|
|
||
|
||||||||||||||||||||||||||||||||||||||||||||||||||||||||
| ▼買い物かご |
|
|
||
| 「ミスパ ビューティー・ミニ」データ | ||
|
|
||
|
| ▼買い物かご |
|
|
||
| 「ミスパ ビューティー・ミニ」Q&A | ||
|
|
||
|
| ▼買い物かご |

ストレスが溜まっていると感じたとき、ついつい甘いものやアルコールに頼ってしまいます。ストレスにいい食べ物はあるのでしょうか?(毎日忙しくて疲れ気味の30代主婦)
ストレスが溜まっていると感じたとき、ついつい甘いものやアルコールに頼ってしまいます。ストレスにいい食べ物はあるのでしょうか?(毎日忙しくて疲れ気味の30代主婦)


